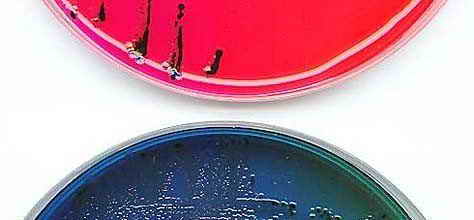

Интересное в августе в глобальной сети
August 31, 2008
В августе мы очень хотели, но не смогли написать о следующем:
- На 3-ёх километровой глубине Атлантического океана в гидротермических источниках, известных как «чёрные курильщики» обнаружена самая горячая вода на планете, её температура составляет 407°C
- Фотографии адронного коллайдера крупным планом
- 48% всех живущих на Земле приматов находятся под угрозой вымирания
- Найдены остатки живых организмов, обитавших в Антарктиде 14 млн лет назад. 200000 лет назад в Антарктиде летние температуры были выше на 8 градусов, чем теперь, а климат был схож с умеренным климатом Патагонии Южной Америки.
- Под Северным Ледовитым океаном скрыта пятая часть не разведанных мировых запасов углеводородов и как минимум шесть стран будут претендовать на эти ресурсы.
- Глобальное потепление будет сопровождаться катастрофическими дождями. Интенсивность выпадения осадков будет значительно выше, чем предсказывалось ранее.
- Учёные установили, что процессы старения организма происходят вследствие ошибок транскрипции и репликации ДНК, а также трансляции генетической информации в молекулы белка. Накопленные ошибочные молекулы «зашлаковывают» клетки, вызывая их старение. В лабораторных условиях удалось остановить процессы старения клеток печени мышей, активизировав работу лизосом клетки.
- Чешский фотограф Мирослав Тихий (Miroslav Tichy) изготавливал свои камеры из того, что смог найти на помойке. В ход шло все — от консервных банок до линз от очков. Его считали сумасшедшим отшельником, но это его вовсе не волновало. Мирослав Тихий бродил по городу в лохмотьях и фотографировал женщин на самодельный фотоаппарат. Прошли годы и его «открыли» — бывший бродяга стал знаменитостью, его фотографии стоят десятки тысяч евро и выставляются в лучших галереях.


- Метеорологи: 2008 год станет самым прохладным за последние 8 лет
- Полимер хитозан начинает активно использоваться для защиты сельскохозяйственной продукции от вредителей в Узбекистане.
- Хабр со ссылкой на LiveScience приводит список актуальных достижений современной бионики
- Очень интересная статья о человеческой неразумности
Эти факты особенно меня заставили задуматься:
+ в отличие от любых зверей, человек способен с невероятной жестокостью убивать себе подобных. Учеными подсчитано, что за последние 6 тысяч лет люди пережили 14 513 войн, в которых погибло 3640 млн человек;
+ война постоянно «дорожает». Если затраты на первую мировую войну составляли 50 млрд рублей, то вторая обошлась уже в десять раз дороже;
+ в конце 80-х лет затраты на вооружение в мире составляли уже 1 триллион долларов! Это превышает ассигнование всех стран мира на медицину, образование и жилищное строительство. Не говоря уже об экологии, т.е. человечество сознательно вкладывает деньги в технологии, которые увеличивают вероятность наступления глобального экологического кризиса, вместо того, чтобы работать над технологиями, защищающими Землю от растущего антропогенного прессинга.
- Попкорн опасен для здоровья, всему виной ароматизатор диацетил, который добавляется к маслу, входящему в состав полуфабриката попкорна. Диацетил в больших концентрациях способен вызывать тяжёлые лёгочные заболевания.
- 10 удивительных фактов о животных приводит iScience.ru
- Крупнорогатый скот на пастбище выстраивается параллельно линии север-юг, об этом сообщает Greenword. Так ли это? Надо будет как-нибудь понаблюдать на практике.
- Занимательные факты из области географии приводит умный блог.
- Последствия, от сброшенной на японский город Нагасаки атомной бомбы 9 августа 1942 года, заметны по сей день, спустя 63 года. Взрыв бомбы вызвал гибель 74 тыс. человек и разрушение 51 тыс. домов. США единственная страна мира, которая использовала ядерное оружие против мирного населения.

- На 3-ёх километровой глубине Атлантического океана в гидротермических источниках, известных как «чёрные курильщики» обнаружена самая горячая вода на планете, её температура составляет 407°C
- Фотографии адронного коллайдера крупным планом
- 48% всех живущих на Земле приматов находятся под угрозой вымирания
- Найдены остатки живых организмов, обитавших в Антарктиде 14 млн лет назад. 200000 лет назад в Антарктиде летние температуры были выше на 8 градусов, чем теперь, а климат был схож с умеренным климатом Патагонии Южной Америки.
- Под Северным Ледовитым океаном скрыта пятая часть не разведанных мировых запасов углеводородов и как минимум шесть стран будут претендовать на эти ресурсы.
- Глобальное потепление будет сопровождаться катастрофическими дождями. Интенсивность выпадения осадков будет значительно выше, чем предсказывалось ранее.
- Учёные установили, что процессы старения организма происходят вследствие ошибок транскрипции и репликации ДНК, а также трансляции генетической информации в молекулы белка. Накопленные ошибочные молекулы «зашлаковывают» клетки, вызывая их старение. В лабораторных условиях удалось остановить процессы старения клеток печени мышей, активизировав работу лизосом клетки.
- Чешский фотограф Мирослав Тихий (Miroslav Tichy) изготавливал свои камеры из того, что смог найти на помойке. В ход шло все — от консервных банок до линз от очков. Его считали сумасшедшим отшельником, но это его вовсе не волновало. Мирослав Тихий бродил по городу в лохмотьях и фотографировал женщин на самодельный фотоаппарат. Прошли годы и его «открыли» — бывший бродяга стал знаменитостью, его фотографии стоят десятки тысяч евро и выставляются в лучших галереях.


- Метеорологи: 2008 год станет самым прохладным за последние 8 лет
- Полимер хитозан начинает активно использоваться для защиты сельскохозяйственной продукции от вредителей в Узбекистане.
- Хабр со ссылкой на LiveScience приводит список актуальных достижений современной бионики
- Очень интересная статья о человеческой неразумности
Эти факты особенно меня заставили задуматься:
+ в отличие от любых зверей, человек способен с невероятной жестокостью убивать себе подобных. Учеными подсчитано, что за последние 6 тысяч лет люди пережили 14 513 войн, в которых погибло 3640 млн человек;
+ война постоянно «дорожает». Если затраты на первую мировую войну составляли 50 млрд рублей, то вторая обошлась уже в десять раз дороже;
+ в конце 80-х лет затраты на вооружение в мире составляли уже 1 триллион долларов! Это превышает ассигнование всех стран мира на медицину, образование и жилищное строительство. Не говоря уже об экологии, т.е. человечество сознательно вкладывает деньги в технологии, которые увеличивают вероятность наступления глобального экологического кризиса, вместо того, чтобы работать над технологиями, защищающими Землю от растущего антропогенного прессинга.
- Попкорн опасен для здоровья, всему виной ароматизатор диацетил, который добавляется к маслу, входящему в состав полуфабриката попкорна. Диацетил в больших концентрациях способен вызывать тяжёлые лёгочные заболевания.
- 10 удивительных фактов о животных приводит iScience.ru
- Крупнорогатый скот на пастбище выстраивается параллельно линии север-юг, об этом сообщает Greenword. Так ли это? Надо будет как-нибудь понаблюдать на практике.
- Занимательные факты из области географии приводит умный блог.
- Последствия, от сброшенной на японский город Нагасаки атомной бомбы 9 августа 1942 года, заметны по сей день, спустя 63 года. Взрыв бомбы вызвал гибель 74 тыс. человек и разрушение 51 тыс. домов. США единственная страна мира, которая использовала ядерное оружие против мирного населения.